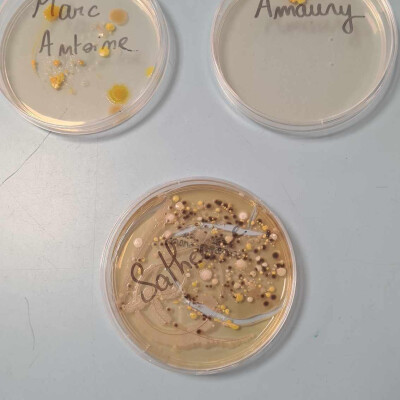
Chercheur à l'école Vannina Lorenzi CE2 CM Ecole de Carbuccia cover

Description
Frequenza Nostra, c’est un peu comme la bébête qui monte, qui monte… et qui fait des guiliguilis dans les oreilles des auditeurs. Radio associative et de proximité, elle est un rendez-vous quotidien, un lieu de rencontres et de partages. On y vient pour parler de soi et des autres, pour raconter son île, sa ville, son village. On y disserte – en français ou en corse – sur l’environnement, la société, l’économie, l’histoire, la musique, l’art, le bien-être, bref, sur le monde. Frequenza Nostra, c’est aussi la voix de celles et ceux qui n'ont que trop rarement la parole, notamment les personnes précaires, en situation de handicap ou en perte d’autonomie, les enfants et toutes celles et ceux que la vie a fragilisés. D’ailleurs, sur le 99 FM, même les animaux ont la parole !
Hébergé par Ausha. Visitez ausha.co/politique-de-confidentialite pour plus d'informations.